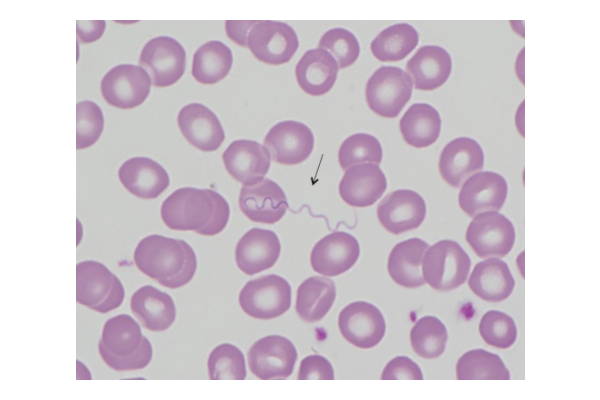

Borrelia miyamotoi is a spirochetal bacterium that is a member of the relapsing fever group of Borrelia. It was first discovered in Japan in 1995, but did not cause its first case of human disease in the United States until 2013. It is transmitted by the same tick species that transmits Lyme disease, Ixodes scapularis. B. miyamotoi is geographically widespread. A survey of nymphal Ixodes scapularis ticks in 11 Lyme disease–endemic states reported that 2% were infected with B miyamotoi and 20% with B burgdorferi.
Unlike with Lyme disease, patients infected with B miyamotoi typically do not develop a rash. The most common clinical presentation is fever accompanied by headache (96%), myalgia (84%), arthralgia (76%), and malaise/fatigue (82%). Fever may be relapsing in untreated patients. Severely immunocompromised patients may develop chronic meningitis.
Laboratory abnormalities include elevated liver enzymes in 75% of patients, leukopenia in 51% and thrombocytopenia in 60%. Leukopenia and thrombocytopenia are less commonly observed in patients with Lyme disease.
Both doxycycline and amoxicillin appear to be effective for treatment of immunocompetent patients with this infection.
The preferred test for detecting B. Miyamotoi is real-time polymerase chain reaction (PCR) that targets the glycerophosphodiester phosphodiesterase (glpQ) gene. Either blood or cerebrospinal fluid can be tested. A positive result indicates the presence of Borrelia miyamotoi DNA and is consistent with active or recent infection.
Specimen requirement is a lavender top (EDTA) tube of blood or 1 mL of cerebrospinal fluid.
References
Molloy PJ, Telford SR III, Chowdri HR, et al. Borrelia miyamotoi disease in the northeastern United States: a case series. Ann Intern Med. 2015; 163(2):91-98.
Cleveland DW, Anderson CC, Brissette CA. Borrelia miyamotoi: A Comprehensive Review. Pathogens. 2023 Feb 7;12(2):267. doi: 10.3390/pathogens12020267.

How to resolve AdBlock issue?
How to resolve AdBlock issue?